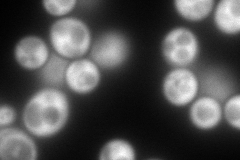
YML070W
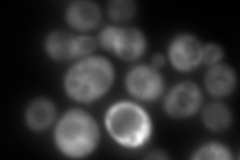
YML070W
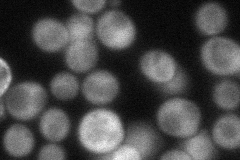
YML070W
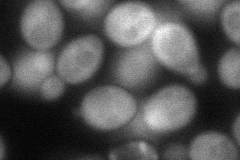
YML070W
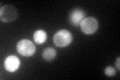
YML070W

View description
Dihydroxyacetone kinase, required for detoxification of dihydroxyacetone (DHA); involved in stress adaptation
Localization:
Intensity:
Fold change:
Significance:
-
C’ GFP library in SD

cytosol91.54 -
N' NOP1pr-GFP in SD
cytosol317.201 -
N' TEF2pr-mCherry in SD
cytosol26.7571 -
N' NATIVEpr-GFP in SD
cytosol68.7451 -
N' TEF2pr-VC and Cyto-VN in SD
cytosol84.6008 -
C’ GFP library in SD+DTT

cytosol153.711.67Yes -
C’ GFP library in SD+H2O2

cytosol122.291.33No -
C’ GFP library in Starvation Media
cytosol149.871.63Yes -
C’ GFP library on the background of Pup2-DaMP

cytosol -
C’ GFP library on the background of CCT mutant

cytosol117.4181.28259No
